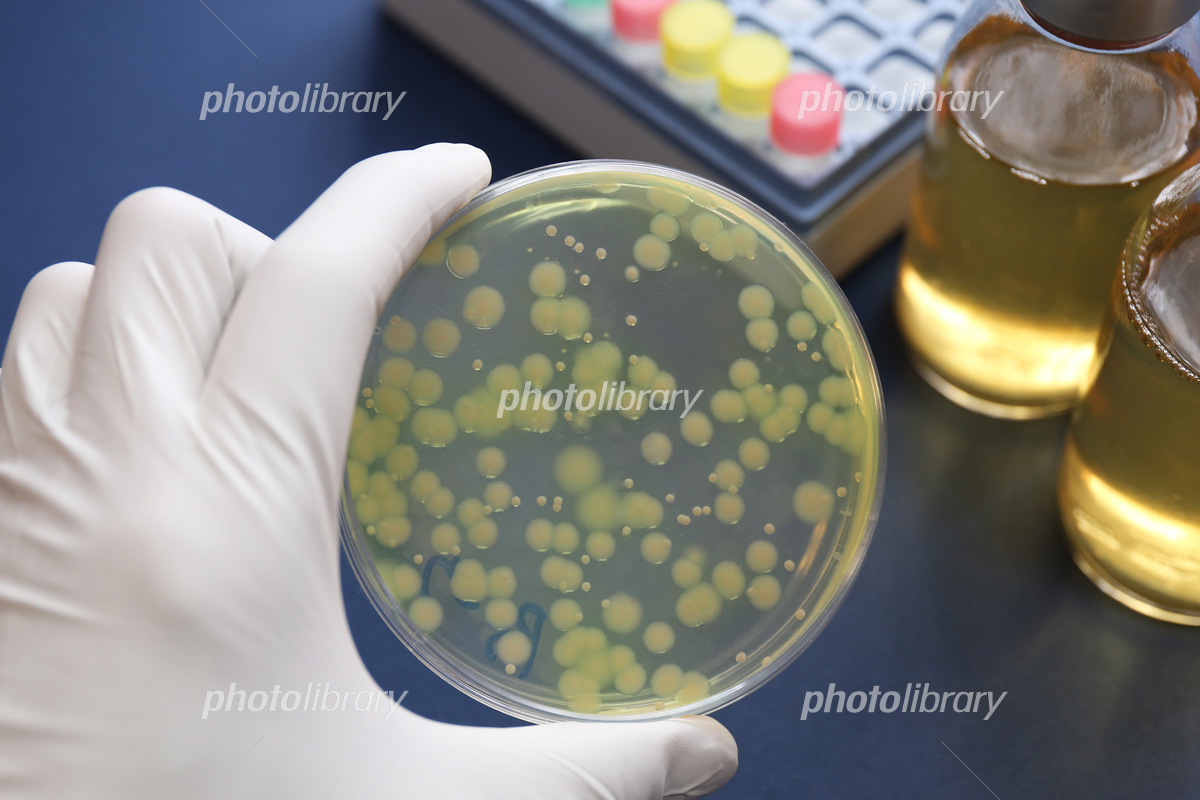

ホワイトキス とは (455 無料画像)
キス KITH × Salomon 2025年春夏 XT-Whisper スニーカー ホワイト系 サイズ27cmメンズ。
楽譜 ホワイトキス鈴木 鈴木ピアノソロ中級- Piascore 楽譜ストア。
Taylor Made KITH コラボキャップ ホワイト キス」がゴルフブランド「テーラーメイド」と初コラボ ゴルフ用品。
レア 新品 kith seoul 韓国限定 Tシャツ ホワイト XL キス。
❄️ 鈴木鈴木「ホワイトキス」:冬の恋が輝くラブストーリー ❄️ – ボイトレならNAYUTAS ナユタス。
伊勢半公式通販 キス マットシフォン UVホワイトニングベースN医薬部外品商品情報伊勢半オンラインストア – ISEHANonline store。
鈴木鈴木「ホワイトキス」の歌詞の意味は?186日の理由や贈り物の正体も考察!歌詞検索サイト UtaTen ふりがな付。
ホワイトキス - 鈴木鈴木 Official Music Video- YouTube。
KITH Tシャツ 半袖 波ロゴ イラスト クルーネック 古着 カジュアル メンズ Sサイズ ホワイト キス トップス A13746◇ :サンステップ Yahoo!店 - 通販 - Yahoo!ショッピング。
HERSHEY'Sハーシー キス リップスクラブ < ホワイトカカオの香り > HS20148粧美堂オンラインストア公式。
ホワイトキス - 鈴木鈴木 Official Music Video。
ホワイトキス 歌詞 海蔵亮太 ふりがな付 - うたてん。
ホワイトキス鈴木鈴木 LIVE at LINE CUBE SHIBUYA。
キャット オブジェ キス "ホワイト"フィンランドで生まれた猫のオブジェBRANDS,Eero AarnioDETAILONLINE STORE。
ホワイトキス - 鈴木鈴木 Official Music Video- YouTube。
KITH スターウォーズ ロングTシャツ M ホワイト キス ハイライト。
ホワイトキス - 鈴木鈴木 Official Music Video- YouTube。
KITH Tシャツ 半袖 波ロゴ イラスト クルーネック 古着 カジュアル メンズ Sサイズ ホワイト キス トップス A13746◇ :サンステップ Yahoo!店 - 通販 - Yahoo!ショッピング。
KITH キス18AW Got Milk Milk Splash Tee ミルク ボックス ロゴ Tシャツ S ホワイト コラボ。
鈴木鈴木、代表曲「ホワイトキス」に次ぐクリスマスソング配信 - 音楽ナタリ。
ホワイトキスのMVの時の写真!! 多摩センターのイルミネーションめっちゃ綺麗だった😆 ういちゃんの可愛い写真載せとくね👍 鈴木鈴木ホワイトキス。
楽譜ホワイトキス鈴木鈴木1コーラス鈴木 鈴木ピアノソロ初級- Piascore 楽譜ストア。
MV1,000万回再生突破!大バズり曲「ホワイトキス」でお馴染み「鈴木鈴木」の新曲ウィンターソングMVヒロイン出演権争奪戦イベント開催決定!〜ミュージックビデオ出演権獲得を目指せ!〜- 17LIVE イチナナ 公式サイト ライブ配信アプリ。
中居正広命名でも話題・鈴木鈴木、2度目の「サツコレ」登場で美声披露「ホワイトキス」では“撮影可能”ステージも<札幌コレクション 2022 A W> -モデルプレス。
歌い方解説 鈴木鈴木「ホワイトキス」by yuki先生♪ナユタス北九州小倉校 – ボイトレならNAYUTAS ナユタス。
平泉 春奈さんはInstagramを利用しています:「・ 『ホワイト・キス』 ・ ・ 皆さん、キスシーンは好きですか? 私は好きです。 ・漫画、ドラマ、映画、全てにおいてキスシーンは最も重要で心が動くシーンです。 その一コマで、切なさだったり、愛しさだったり、優しさ。
ホワイトキス鈴木鈴木 , 誰の声がタイプ?ホワイトキス鈴木鈴木。
ティファ ホワイトキス INHALE ウルトラセンシティブ 180 アウトドア用品・釣り具通販はナチュラム。
2021年クリスマスソングの大本命? 鈴木鈴木「ホワイトキス」がTikTokで大ヒット中 - Real Soundリアルサウンド。
歌詞付きホワイトキス - 鈴木鈴木 - YouTube。
ホワイトキス鈴木鈴木 Acoustic ver feat.たいせー - YouTube。
HERSHEY'Sハーシー キス ハンドクリーム <ホワイトカカオの香り> HS20151粧美堂オンラインストア公式。
キャット オブジェ キス "ホワイト"フィンランドで生まれた猫のオブジェBRANDS,Eero AarnioDETAILONLINE STORE。
マットシフォン UVホワイトニングベースN私は、私に、kissをするKiSS キスKISSME。
ホワイトキス - ゆうたとるなコラボ動画TikTok。
鈴木鈴木「ホワイトキス」のMVにせりしゅん出てるよーーー😆 とむくんせいなくん歌上手すぎてやばいな、、 今年の冬はホワイトキスで決まり👍 みんないっぱい聴いてね〜 鈴木鈴木ホワイトキス。
キャット オブジェ キス "ホワイト"フィンランドで生まれた猫のオブジェBRANDS,Eero AarnioDETAILONLINE STORE。
KITH Tシャツ 半袖 波ロゴ イラスト クルーネック 古着 カジュアル メンズ Sサイズ ホワイト キス トップス A13746◇ :サンステップ Yahoo!店 - 通販 - Yahoo!ショッピング。
KITH スターウォーズ ロングTシャツ M ホワイト キス ハイライト。
ホワイトキス Acoustic ver.2023。
2021年クリスマスソングの大本命? 鈴木鈴木「ホワイトキス」がTikTokで大ヒット中 - Real Soundリアルサウンド。
ホワイトキスはそう君だけホワイトキス 鈴木鈴木歌詞 XmasTikTok。
KITH スターウォーズ ロングTシャツ M ホワイト キス ハイライト。
鈴木鈴木、代表曲「ホワイトキス」に次ぐクリスマスソング配信 - 音楽ナタリ。
ホワイトキス鈴木鈴木 Acoustic Ver. 2023。
KITH Tシャツ 半袖 波ロゴ イラスト クルーネック 古着 カジュアル メンズ Sサイズ ホワイト キス トップス A13746◇ :サンステップ Yahoo!店 - 通販 - Yahoo!ショッピング。
キス」の眉コンシーラー“うす眉メーカー”から限定色ホワイトベージュ 地肌に限りなく近い明るさ - WWDJAPAN。
楽譜一覧 ホワイトキス - ヤマハ「ぷりんと楽譜」。
ホワイトキス - 鈴木鈴木 Official Music Video- YouTube。
ホワイトキス デジタル配信- 鈴木鈴木 - UNIVERSAL MUSIC JAPAN。
KITH Tシャツ 半袖 波ロゴ イラスト クルーネック 古着 カジュアル メンズ Sサイズ ホワイト キス トップス A13746◇ :サンステップ Yahoo!店 - 通販 - Yahoo!ショッピング。